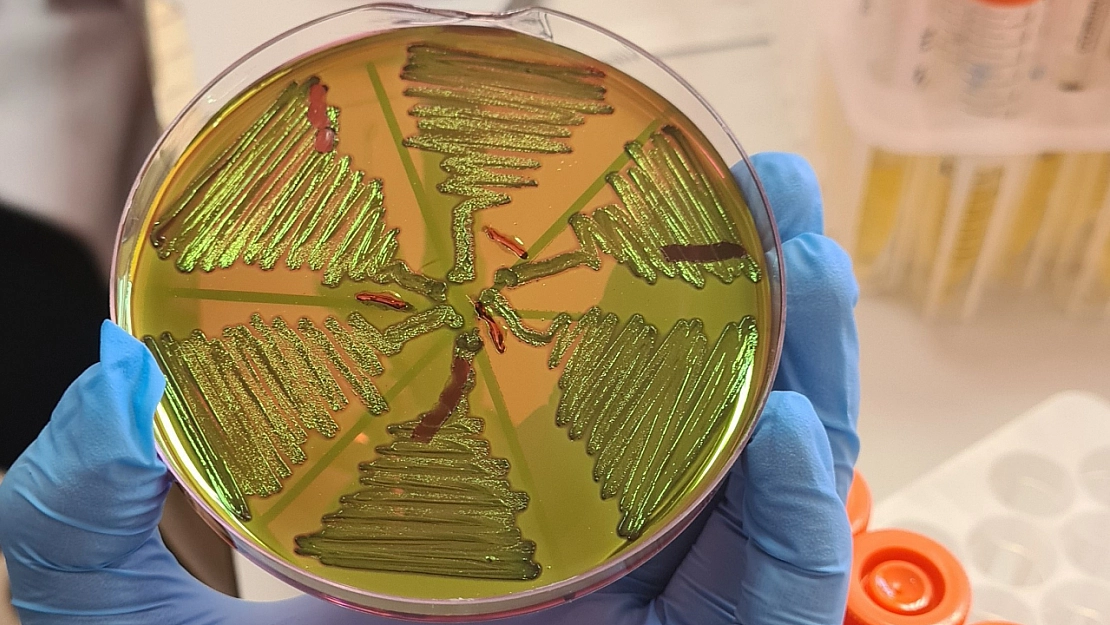
Malatya'da 122 çiğ süt örneği korkuttu! Kaynatmak yetmeyebilir!

- Haberler
- Video Haber
- Malatya'da 122 çiğ süt örneği korkuttu! Kaynatmak yetmeyebilir!
Malatya'da 122 çiğ süt örneği korkuttu! Kaynatmak yetmeyebilir!
İnönü Üniversitesi Fen-Edebiyat Fakültesi Biyoteknoloji Anabilim Dalı tarafından yapılan bir çalışmada, Malatya kırsalından alınan 122 çiğ süt örneğinde bulunan bazı bakterilerin, süt yoluyla vücuda girdiği ve özellikle kadınlar, yaşlı bireyler ve bağışıklığı zayıf kişiler için büyük risk barındırdığı gözler önüne serildi.
Bakmadan Geçme

Malatya için peş peşe uyarı: Yüksek kesimlere dikkat!

Vali Yavuz duyurdu: Malatya’da eğitme ara!

Pazar tezgahlarındaki fiyatlar dondu! ‘Pazara giden eli boş dönüyor’

15 günlük süre sona erdi: Küçük Sanayi esnafından son çağrı!

Mersin milletvekili konuştu, Malatya'nın 6 vekili suskun

TOKİ 500 bin konut projesi Malatya kura çekimi tarihi belli oldu!